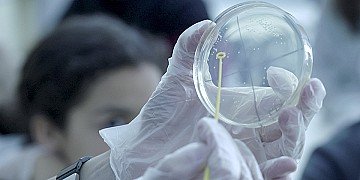
Press Release cover image

Compatibilità
Salva(0)
-
Es tracta de vuit expedicions que operen a partir d’avui
El Departament de Territori, Habitatge i Transició Ecològica, conjuntament amb l’empresa operadora TEISA, incorporen vuit noves expedicions, a partir d’avui 01 de desembre, en el corredor que enllaça les ciutats de Girona, Banyoles i Olot.
En concret, les noves expedicions són:
- A les 06:45h des de Girona, passant a les 07:15h per Banyoles i arribant a les 08:00h a Olot (amb parada Besalú).
- A les 09:00h des de Girona, passant a les 09:30h per Banyoles i arribant a les 10:15h a Olot (amb parada Besalú).
- A les 14:45h des de Girona, passant a les 15:15h per Banyoles i arribant a les 16:00h a Olot (amb parada Besalú).
- A les 16:45h des de Girona, passant a les 17:15h per Banyoles i arribant a les 18:00h a Olot (amb parada Besalú).
- A les 07:15h des d’Olot, passant a les 08:05h per Banyoles i arribant a les 08:30h a Girona (amb parada Besalú).
- A les 08:15h des d’Olot, passant a les 09:05h per Banyoles i arribant a les 09:30h a Girona (amb parada Besalú).
- A les 15:00h des d’Olot, passant a les 15:50h per Banyoles i arribant a les 16:15h a Girona (amb parada Besalú).
- A les 16:00h des d’Olot, passant a les 16:50h per Banyoles i arribant a les 17:15h a Girona (amb parada Besalú).
Foto: Gencat
Jordi